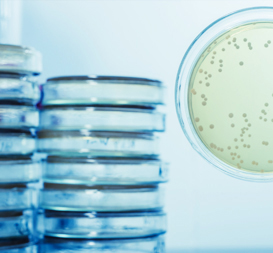
Petri dishes stacked

Our range of water services
We offer a comprehensive range of water management solutions, designed to help you comply with the legislation around legionella control, as well as save you water and money.

Water hygiene
Including legionella risk assessments, monitoring and maintenance, electronic log books and cleaning and disinfection services.


Water treatment
Including treatment of cooling towers, steam boilers, humidifiers, water softening and wastewater treatment. We also provide a complete range of chemical solutions tailored to meet all your specific water treatment needs.


Water management
Including water audits, alternative water sources and water efficiency solutions.


Commercial heating
Including servicing, maintenance, refurbishment and replacement of plant, water tanks and commercial boilers.
About us
We are experts in legionella control and help businesses keep their water systems compliant with ACoP L8 by carrying out the necessary risk assessments and any subsequent legionella treatments. We also have a commercial heating and plumbing team who specialise in refurbishing large plant rooms.
At AquaCare, we have over fifteen years’ experience providing water hygiene services, water treatment and water monitoring for businesses across the South. We're part of the Pennon Group, a FTSE 350 company, so you know you're in safe hands.
We have a broad portfolio of customers including educational, commercial, industrial and public sector organisations. You can find out more about some of our success stories here.
Our key sectors
We have a broad portfolio of customers including commercial, industrial and public sector organisations.

Care homes and hospitals
Residents of care homes and hospitals are vulnerable to contracting Legionnaires' disease due to their age, frailty and compromised immune systems.

Education
Many school buildings, both public and private contain old, adapted water systems providing the perfect breeding ground for legionella.

Leisure and tourism
Holiday parks, hotels and sports centres with swimming pools, spas, restaurants and shower blocks all need to ensure their water is safe to protect their staff, customers and reputation.

Manufacturing
For most industrial facilities, clean water is vital as failure to provide good water quality can lead to maintenance and repair.



